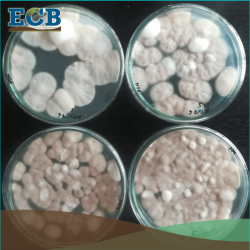
ECB ecocyclebiotech investigación biotecnología para la agricultura
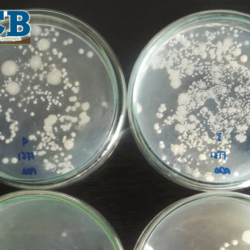
ECB Bioinsumos para la agricultura biotecnología ecocyclebiotech

Investigación
- Inicio
- Investigación

CONTROL DE PSEUDOCOCCUS VIBURNI
Este insecto plaga conocido como Cochinilla harinosa, es común en cultivos como cacao, piña, banano, etc. Nuestras investigaciones con hongos
Aliados Estratégicos
Temas de Investigación

Extractos botánicos para control de plagas como pulgón, ácaros, cochinilla, mosca blanca, gallina ciega, otros.
Hongos entomopatógenos para control de plagas en cultivos de banano, brocoli, malanga, piña, uvilla, frutales, cítricos,otros.

Pudrición del cogollo en palma africana

Bacterias fijadoras de nitrógeno
Bacterias solubilizadoras de calcio

Bacterias antagonistas de patógenos
¿Deseas más información?
- 0987363262
- comunicacion@ecbiotech.com
